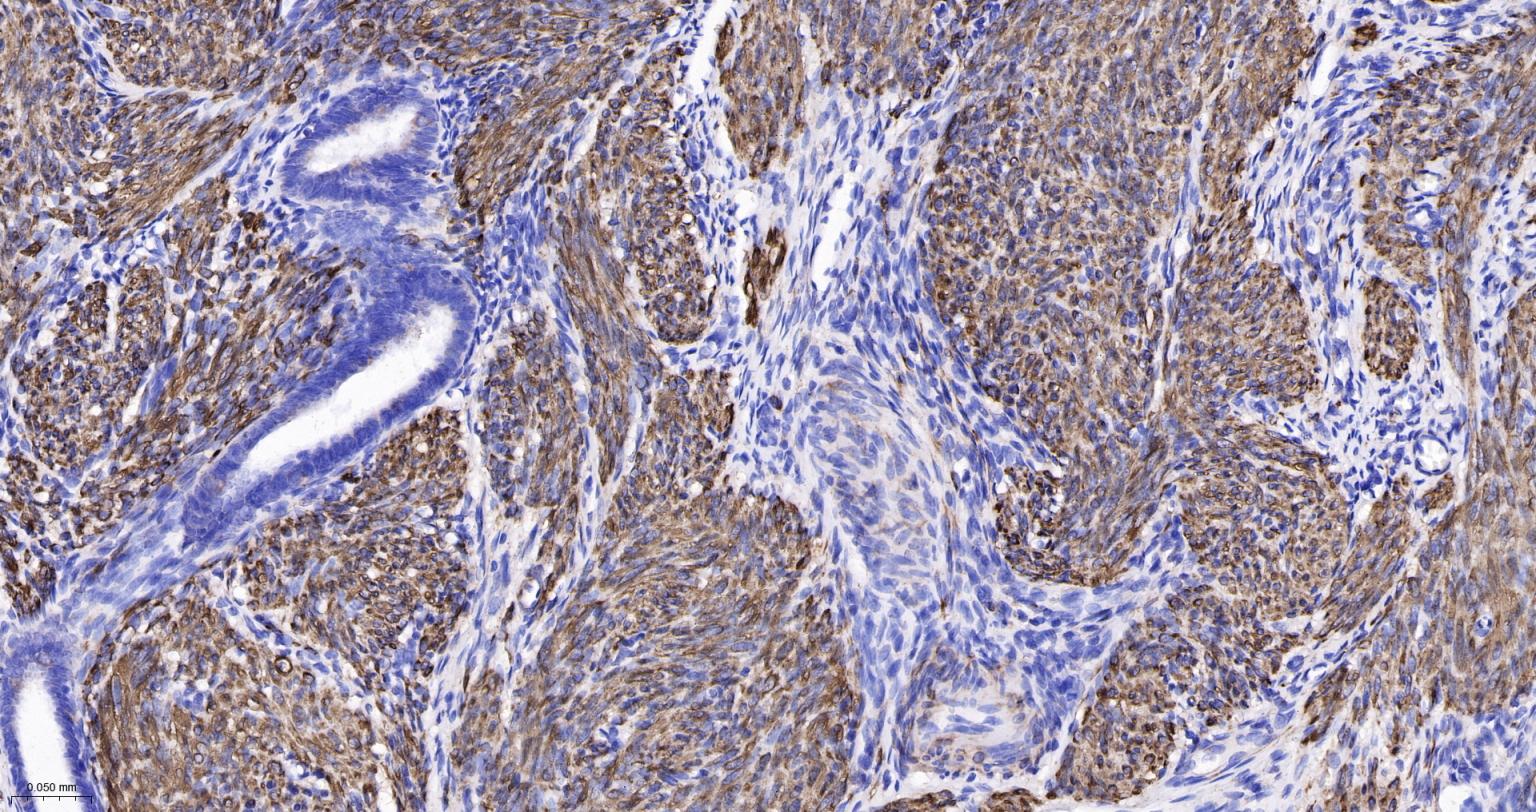
结蛋白重组兔单抗

Desmin Recombinant Rabbit mAb (一抗) - WB,IHC-P,IHC-F,IF,ICC/IF | Bioss
Rrmab?兔单抗

货号:bsm-60266R
产品详情
相关标记
相关产品
相关文献
常见问题
概述
产品编号
bsm-60266R
产品类型
重组兔单抗、病理级抗体、mIHC精品抗体
英文名称
Desmin Recombinant Rabbit mAb
中文名称
结蛋白重组兔单抗
英文别名
CDCD3; CSM1; CSM2; LGMD1D; LGMD1E; LGMD2R; DESM_HUMAN; DES; DESM_MOUSE; DESM_RAT;
抗体来源
Rabbit
免疫原
A synthesized peptide derived from human Desmin: 410-470
亚型
IgG
性状
Liquid
纯化方法
affinity purified by Protein A
克隆类型
Recombinant
克隆号
3B9
理论分子量
52 kDa
检测分子量
53 kDa
浓度
1mg/ml
储存液
0.01M TBS (pH7.4) with 1% BSA, 0.02% Proclin300 and 50% Glycerol.
研究领域
SWISS
Gene ID
保存条件
Shipped at 4℃. Store at -20℃ for one year. Avoid repeated freeze/thaw cycles.
注意事项
This product as supplied is intended for research use only, not for use in human, therapeutic or diagnostic applications.
数据库链接
产品介绍
Desmin在很多哺乳动物中的横纹肌和各种平滑肌及其来源的肿瘤组织中都有表达。结蛋白是一种中间丝蛋白,广泛分布于骨骼肌细胞、平滑肌细胞、心肌细胞和肌上皮细胞及其肿瘤中,主要用于子宫、皮肤、胃肠道及其它横纹肌肉瘤和肌上皮瘤的诊断和鉴别诊断。
背景资料
Desmin is a muscle-specific, type III intermediate filament that integrates the sarcolemma, Z disk, and nuclear membrane in sarcomeres and regulates sarcomere architecture. In adult striated muscle they form a fibrous network connecting myofibrils to each other and to the plasma membrane from the periphery of the Z line structures. Defects in Desmin are the cause of desmin related cardio skeletal myopathy (CSM) also known as desmin related myopathy (DRM). CSM is characterized by skeletal muscle weakness associated with cardiac conduction blocks, arrhythmias, restrictive heart failure, and by intracytoplasmic accumulation of desmin reactive deposits in cardiac and skeletal muscle cells. A desmin related myopathy can have a distal onset, it is then known as hereditary distal myopathy (HDM). Defects in Desmin are also the cause of dilated cardiomyopathy type 1I (CMD1I). CMD1I is an autosomal form of dilated cardiomyopathy characterized by ventricular dilatation and impaired systolic function. Antidesmin antibodies are useful in identification of tumours of myogenic origin

产品应用
| 应用 | 已检合格种属 | 预测种属 | 推荐稀释比例 |
|---|---|---|---|
| WB | Human, Mouse, Rat | 1:1000-5000 | |
| IHC-P | Human, Mouse, Rat | 1:200-800 | |
| IHC-F | Human, Mouse, Rat | 1:200-800 | |
| IF | Human, Mouse, Rat | 1:200-800 | |
| ICC/IF | Mouse | Human, Rat | 1:100-500 |
交叉反应
交叉反应: Human, Mouse, Rat
相关产品
暂无相关产品
靶标
基因名
DES
蛋白名
Desmin
亚基
Homopolymer. Interacts with DST. Interacts with MTM1.
亚细胞定位
Cytoplasm.
翻译后修饰
ADP-ribosylation prevents ability to form intermediate filaments.
疾病
Defects in DES are the cause of myopathy myofibrillar type 1 (MFM1) [MIM:601419]. A neuromuscular disorder characterized by skeletal muscle weakness associated with cardiac conduction blocks, arrhythmias, restrictive heart failure, and by myofibrillar destruction with intracytoplasmic accumulation of desmin-reactive deposits in cardiac and skeletal muscle cells. Note=Mutations in the DES gene are associated with a variable clinical phenotype which encompasses isolated myopathies, pure cardiac phenotypes (including dilated cardiomyopathy, restrictive cardiomyopathy and arrhythmogenic right ventricular cardiomyopathy), cardiac conduction disease, and combinations of these disorders. If both cardiologic and neurologic features occur, they can manifest in any order, as cardiologic features can precede, occur simultaneously with, or follow manifestation of generalized neuromuscular disease (PubMed:19879535).
Defects in DES are the cause of cardiomyopathy dilated type 1I (CMD1I) [MIM:604765]. Dilated cardiomyopathy is a disorder characterized by ventricular dilation and impaired systolic function, resulting in congestive heart failure and arrhythmia. Patients are at risk of premature death.
Defects in DES are the cause of neurogenic scapuloperoneal syndrome Kaeser type (Kaeser syndrome) [MIM:181400]. Kaeser syndrome is an autosomal dominant disorder with a peculiar scapuloperoneal distribution of weakness and atrophy. A large clinical variability is observed ranging from scapuloperoneal, limb grindle and distal phenotypes with variable cardiac or respiratory involvement. Facial weakness, dysphagia and gynaecomastia are frequent additional symptoms. Affected men seemingly bear a higher risk of sudden, cardiac death as compared to affected women. Histological and immunohistochemical examination of muscle biopsy specimens reveal a wide spectrum of findings ranging from near normal or unspecific pathology to typical, myofibrillar changes with accumulation of desmin.
Defects in DES are the cause of cardiomyopathy dilated type 1I (CMD1I) [MIM:604765]. Dilated cardiomyopathy is a disorder characterized by ventricular dilation and impaired systolic function, resulting in congestive heart failure and arrhythmia. Patients are at risk of premature death.
Defects in DES are the cause of neurogenic scapuloperoneal syndrome Kaeser type (Kaeser syndrome) [MIM:181400]. Kaeser syndrome is an autosomal dominant disorder with a peculiar scapuloperoneal distribution of weakness and atrophy. A large clinical variability is observed ranging from scapuloperoneal, limb grindle and distal phenotypes with variable cardiac or respiratory involvement. Facial weakness, dysphagia and gynaecomastia are frequent additional symptoms. Affected men seemingly bear a higher risk of sudden, cardiac death as compared to affected women. Histological and immunohistochemical examination of muscle biopsy specimens reveal a wide spectrum of findings ranging from near normal or unspecific pathology to typical, myofibrillar changes with accumulation of desmin.
相似性
Belongs to the intermediate filament family.
功能
Desmin are class-III intermediate filaments found in muscle cells. In adult striated muscle they form a fibrous network connecting myofibrils to each other and to the plasma membrane from the periphery of the Z-line structures.
同靶标产品
相关文献
提示: 发表研究结果有使用 bsm-60266R 时请让我们知道,以便我们可以引用参考文章。作为回馈,资料提供者将获得我们送上的小礼品。